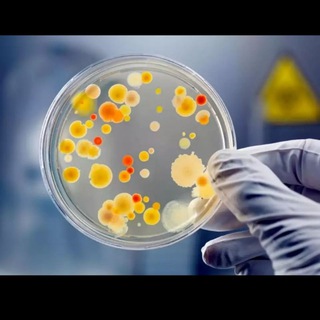
Логотип @microbiologiya - Микробиология

Telegram каналы: Образование
Все
Другое
Чаты
Новости и СМИ
Блоги
Технологии
Образование
Музыка
Игры
Развлечения
Красота
Для взрослых
Фото
Финансы
Магазины и продажи
Политика
Психология
Спорт и фитнес
Здоровье
Региональные
Путешествия
Фильмы и сериалы
Криптовалюты
Цитаты
Религия
Экономика
Дизайн
Еда
Книги
Искусство
Прогнозы и ставки
Карьера
Маркетинг
Авто и мото
Гороскопы и эзотерика
Природа и животные
Для родителей
Языки
Строительство и ремонт
Юриспруденция
Инстаграм
Недвижимость
Рукоделие
Скидки и акции
Аниме
Даркнет
Видео
Бизнес
Война и конфликты
Подкасты
Медицина

Центр развития робототехники (ЦРР)
@robocentervl
1.7K
Вопросы и запись: @robocenteradmin
Обучаем детей 4-18 лет робототехнике, программированию, школьным предметам и готовим победителей к соревнованиям 🏆 Самые актуальные новости на нашем канале, добро пожаловать!

MBBS NEET PG/INCET/NExT
@qexampaper
1.7K
This channel contains PG preparation contents and related questions and most importantly mnemonics. This channel posted daily basis PYQ question or PYQ related contents. So please subscribe this channel and share to your friends as much as possible.

GENUS - найди своих предков
@genuschannel
1.7K
Канал о работе в архивах и восстановлении утерянных страниц семейной историй.
LINK
Сотрудничество - @DimBalashov
Чат для ваших вопросов - LINK

Московская академия Следственного комитета имени А.Я. Сухарева
@academyskrf
1.7K
Официальный канал Московской академии Следственного комитета Российской Федерации имени А.Я. Сухарева.
Сайт➡️ LINK
Официальное сообщество в социальной сети «ВКонтакте»➡️LINK

Школа социальных и экономических наук НИУ ВШЭ
@school_soc_econom
1.7K
Не упусти возможность погрузиться в социальные и экономические науки, университетскую жизнь Вышки и, конечно, пополнить багаж впечатлений и незабываемых эмоций вместе с ШСЭН!😎

Научный трибунал Катющик ТВ
@tribunal100
1.7K
Официальный канал Виктора Катющика
Сайт сообщества Разумная Цивилизация LINK
Связь с админами @Kadry_RC
Для сотрудничества и прессы @Ask_rc

Когда боги смеялись
@lesdeuxontri
1.7K
Кольт, морфий, дирижабль

Школа 1573
@school_1573
1.7K
События, новости, планы – все о нашей школе. Присоединяйтесь!

Институт iSpring
@instituteispring
1.7K
ИТ-вуз с гарантией трудоустройства.
Здесь начинают работать после первого курса, получают высокую квалификацию и добиваются реального результата в ИТ-бизнесе.
По любым вопросам: LINK

ПРОСТРАНСТВО (SPACE)
@elsspace
1.7K
Официальный канал ПРОСТРАНСТВА (SPACE) — пространство твоего роста.
🚀 Здесь найдешь ответы на вопросы, которые помогут увеличить базовые ресурсы — время, деньги и здоровье
Стань частью сильного окружения 👉 elsspace.ru

ИФИБ НИЯУ МИФИ
@physbio_mephi
1.7K
Все главные объявления и новости из жизни Инженерно-Физического Института Биомедицины НИЯУ МИФИ

Myschool Online
@formaproenligne
1.7K

ТЕСТЫ ПО БИОЛОГИИ
@biologiazay
1.7K
Тесты я делаю исходя из учебников Узбекистана. Студентка ТашПМИ (лечебный факультет, грант)
Репетитор по биологии!

Факультет германської філології і перекладу КНЛУ
@germanicphilology_knlu_official
1.7K
Insta: LINK
Довідка про навчання LINK
Довідка про доходи LINK

Арктический лицей
@arctic_lyceum
1.7K
Официальный Telegram-канал «Арктический лицей» города Новый Уренгой
Оставляйте вопросы и комментарии

по связям с общественностью
@pereshli_v_pr
1.7K
Источник идей для рекламных кампаний, мероприятий, коллаб и спецпроектов в университетах и науке
Делитесь своим креативом: @pereshlivpr_bot

АСА | Ассоциация Студентов Адыгеи
@aca01moscow
1.7K
Ассоциация Студентов Адыгеи при Постоянном Представительстве Республики Адыгея при Президенте РФ

Домашний таролог Карпова
@karpovaonline
1.7K
Народный таролог Карпова Е.В.

Умскул Академия
@umschoolvuz
1.7K
Поможем выжить в мире взрослых — сдать сессию без стресса и построить карьеру!
👉🏼 Наш сайт — LINK
Мы в ВК — LINK

CREATIVE TEACHERS
@creatorsteachers
1.7K
Делимся педагогическими проектами.
Контакт для связи: @sahakyanvahan

НТТЭК РЕАЛИТИ
@nt_nttek
1.7K
Официальный канал ГАПОУ СО "Нижнетагильский торгово-экономический колледж".

Кофе съ кисой
@potio_arabica
1.7K
Выписки и размышленiя старѣющаго филолога

Drskool Shop
@drskool_shop
1.7K
Get best medical courses at best prices LINK
Join the Telegram Channel : LINK

Химические полезности| Кандлина Маргарита
@margaretchemist
1.7K
Практические занятия в лаборатории по химии и биологии.
Подготовка к ЕГЭ, ДВИ и ОГЭ по химии. Олимпиада «Ломоносов» по химии.
Для записи на занятия:
✅Мой сайт: LINK
✅ЛС: @kandlina
✅тгк для родителей: LINK
Микробиология
@microbiologiya
1.7K

Археология с ИИМК РАН
@iimk_ran
1.7K
Канал Института истории материальной культуры РАН (Санкт-Петербург)

Руны Вселенной 💜
@runalad
1.7K
🌀 Руны Вселенной и Даарии.
💜 Язык Общения с Богом.
💚 Исцеление Земли.
💙 Обучение Рунам.

Навигатор грантов
@navigatorgrantov
1.7K
Канал о поддержке НКО и социальных предпринимателей.
🔹 Гранты, субсидии и конкурсы
🔹 Обучение и фандрайзинг
🔹 Форумы и конференции
🔹 Законы и актуальные изменения
Автор: Марианна Колыбина, продюсер НКО.
Контакты: mariann-k@yandex.ru

Annunci Scuola - NeoTecno
@annunciscuolaneotecno
1.7K
୧ Canale ufficiale della scuola di NeoTecno!
୧ Bot: @IstitutoGentile_Bot
୧ Discord: LINK

KOSTROMA OPEN
@kostroma_open
1.7K
Информация о проектах KOSTROMA OPEN и около них